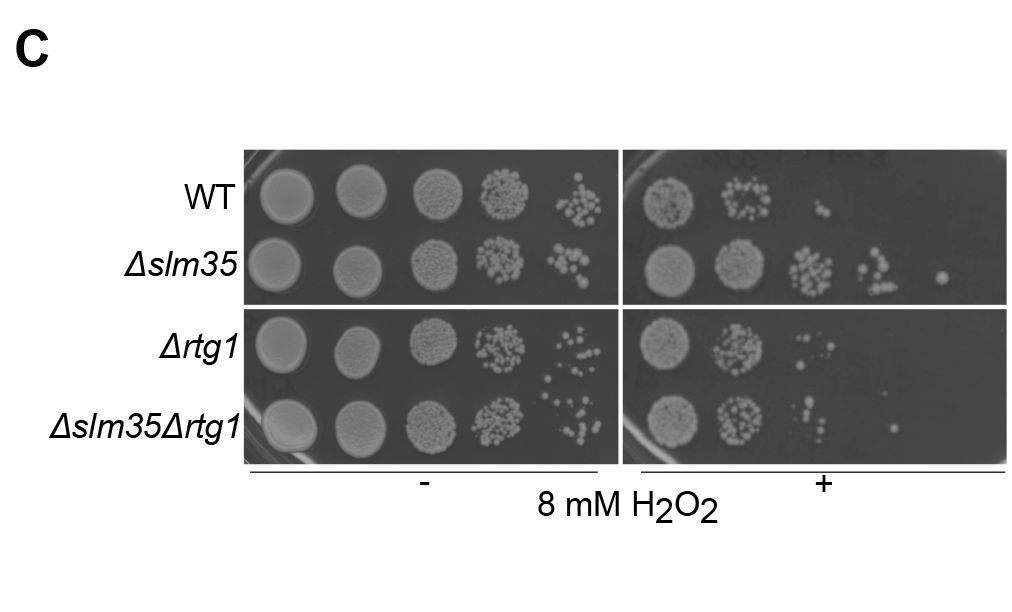
Biology Open tweet media

Sabitlenmiş Tweet

Welcome to Biology Open:
📍 Cambridge, UK
📚 Published by @Co_Biologists
👨🔬 Editor-in-Chief Daniel Gorelick @gorelicklab
🔓 All articles published #OpenAccess
🤝Partnered with @ReviewCommons
🙌Champions #ECRs
Find out more: ow.ly/EF4J50EOg6H
English